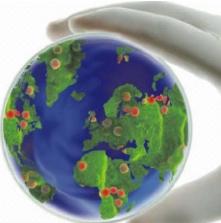

Rodrigo Soto Moreno
 Hace algunos días estuve en una conferencia del doctor Kevin Pixley, investigador del Centro Internacional de Mejoramiento de Maíz y Trigo, y casi al final de su charla él resaltaba la conclusión en relación a que la seguridad alimenticia será cada vez de mayor preocupación. Pero la verdadera sorpresa vino, cuando el doctor Pixley comparó al planeta Tierra con una Placa de Petri, señalando que nos puede suceder lo mismo que a las bacterias cultivadas ahí; pues tienden al colapso al terminarse los recursos limitados, y de cierta forma el planeta podría ser una gran cápsula o caja de Petri, en donde también no existen recursos ilimitados.
Hace algunos días estuve en una conferencia del doctor Kevin Pixley, investigador del Centro Internacional de Mejoramiento de Maíz y Trigo, y casi al final de su charla él resaltaba la conclusión en relación a que la seguridad alimenticia será cada vez de mayor preocupación. Pero la verdadera sorpresa vino, cuando el doctor Pixley comparó al planeta Tierra con una Placa de Petri, señalando que nos puede suceder lo mismo que a las bacterias cultivadas ahí; pues tienden al colapso al terminarse los recursos limitados, y de cierta forma el planeta podría ser una gran cápsula o caja de Petri, en donde también no existen recursos ilimitados.
Esta analogía parte de la premisa en que los seres humanos estamos dentro de este “punto pálido azul”, según lo describe Carl Sagan, y hasta el momento no hemos podido colonizar otro planeta, por lo cual éste es el único lugar al que podemos llamar: hogar. Pero tal vez nos sucede como a la rana, sumergida en agua dentro de una olla, y puesta en una estufa y a la que poco a poco vamos elevando la temperatura; la situación anterior resulta plácida para el anfibio, porque el aumento gradual de los grados es imperceptible, derivando al final en su muerte. Caso contrario si pusiéramos a la rana en agua hirviendo, pues lograríamos que ella buscara su escape, saltando inmediatamente del recipiente. Mi punto es que posiblemente no nos demos cuenta del desgaste que estamos ocasionando a los recursos naturales y me preocupa que cuando “abramos los ojos” sea demasiado tarde.
En este tenor, tal vez podamos tomar el ejemplo de los arrecifes de coral, quienes de acuerdo a Wikipedia, son estructuras subacuáticas hechas con carbonato de calcio, secretado por los corales; descrito de otra forma, Steven Johnson, nos dice que son plataformas biológicas construidas gracias al desecho de productos generados dentro de su propio ecosistema. Por ejemplo, se ha encontrado que existe una importante relación simbiótica, de muchas otras, entre el coral y un alga microscópica denominada zooxantela. Sucede, según Johnson, que el alga absorbe energía del Sol y libera oxígeno y azúcares como desecho, mismos que son aprovechados por los pólipos (animales invertebrados) del coral, para crecer. Por otro lado el coral expulsa dióxido de carbono, nitratos y fosfatos como desecho, sirviendo éstos de combustible para la zooxantela. Tanto la alga como el coral se alimentan de sus desechos.
Otro ejemplo simbiótico del arrecife de coral, lo podemos encontrar en las investigaciones del ecologista alemán, Claudio Richter, quien estudiando a las esponjas que se esconden en las pequeñas cuevas de las estructuras de calcio del coral, encontró que éstas consumen fitoplancton y liberan desechos que también son nutrientes para el arrecife. Es decir, como lo dice Johnson, las esponjas piden refugio de sus depredadores en esas cuevas o grutas e intercambian esa seguridad al soltar nutrientes, para que su huésped excrete aragonita (carbonato de calcio) y creen entonces más habitaciones para albergar más esponjas.
Explicando lo anterior, en palabras de Steven Johnson, esa relación simbiótica entre el coral y la zooxantela incrementa la energía capturada del Sol, así como los ciclos de nutrientes que se reciclan, gracias a la interconexión entre diferentes especies, potenciando los mismos y haciendo más con menos. Es decir, la ingeniería dentro del ecosistema del arrecife coral y el reciclaje de residuos o desechos es vital para la supervivencia entre especies y en este sentido, el propio Johnson nos recuerda que no es la competencia lo que mueve o dirige el proceso del arrecife, sino la inventiva colaboración de la densidad entre especies y el tan mencionado reciclaje de aparentes desechos.
Pero para darnos una idea del valor de los arrecifes de coral, me gustaría hablar de la Gran barrera de coral, localizada en Australia, misma que puede ser observada desde el espacio, pues abarca unos 2,300 kilómetros aproximadamente, en un área de 344,400 kilómetros cuadrados, albergando una gran biodiversidad entre las cuales se cuentan 600 tipos de corales suaves y duros, más de 100 especies de medusas, 3,000 variedades de moluscos, 500 especies de lombrices, 1,625 tipos de peces, 133 variedades de rayas y tiburones, y más de 30 especies de ballenas y delfines, según datos del gobierno australiano. Cabe señalar que este diseño de la naturaleza ha sido catalogado como patrimonio de la Humanidad por la UNESCO.
Volviendo a la formación de los arrecifes, Steven Johnson nos recuerda que el propio Darwin, en su visita a las Islas Keeling, ya describía a pequeños organismos como ingenieros responsables de la tierra que él pisó en ese momento. En este tenor Johnson aprovecha para comentarnos sobre la scleractinia, animales marinos, con un ciclo de vida similar al de un pólipo, generan un exoesqueleto duro, formado por carbonato de calcio o aragonita. Por ello, desde el punto de vista de Johnson, un arrecife de coral es una especie de mausoleo subacuático, donde la unión de millones de exoesqueletos forma un ecosistema laberíntico rico en biodiversidad.
Por todo esto científicos como Clive Jones, han descrito a estas especies como “ingenieros de ecosistemas”, y de acuerdo a Wikipedia: son aquellos que modifican o crean un hábitat y, de acuerdo a Jones, se dividen en: alogénicos, pues modifican el ambiente por medios mecánicos alterando materiales y en autogénicos, quienes al modificarse a sí mismos, cambian el ambiente. Como ejemplo de los primeros, tenemos a los castores, quienes construyen presas y modifican el cauce o flujo del agua; y como ejemplo de los segundos tenemos a los árboles cuando sus troncos sirven de hogar para otros animales.
Es entonces importante remembrar la posición que ocupamos como especie, siendo cercanos a ingenieros de ecosistemas alogénicos, con una huella de impacto importante sobre el planeta, especialmente hacia otros seres vivos, como lo refiere Elizabeth Kolbert cuando habla del Antropoceno. Esta investigadora nos dice textualmente: “El impacto humano, que ha aumentado a un ritmo constante desde la Revolución Industrial, comenzó a crecer exponencialmente después de la Segunda Guerra Mundial, fase que algunos científicos ahora llaman la “gran aceleración”.
El punto de toda esta era, según Paul Crutzen, es que adquiramos conciencia de nuestro paso sobre el planeta y tengamos la capacidad de recapacitar nuestras acciones para mantener la Tierra habitable no solamente para nosotros sino en simbiosis con otras especies. Así como aprender de los arrecifes de coral, quienes a pesar de ocupar menos del 0.1% de la superficie oceánica, dan albergue al 25% de las especies marinas, trabajando en simbiosis colaborativa.
Al final podemos pensar que si en verdad vivimos dentro de una especie de placa de Petri, con recursos limitados, ¿podremos detectar el aumento en la temperatura de esa olla antes de que sea demasiado tarde? ¿Entraremos en razón sobre la importancia de reciclar materiales para maximizar los recursos escasos? ¿Comprenderemos la necesidad de estar en simbiosis con otros ecosistemas? Pues no sabemos, con certeza, cuando esta gran caja de Petri agote sus recursos y no tenga más que ofrecernos y por lo pronto es nuestro único hogar.